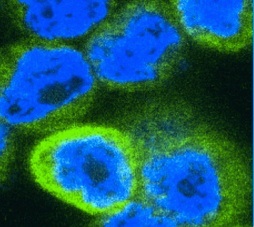

Home
Welcome
The Smurfit Institute of Genetics is an academic unit of Trinity College Dublin. Together with the Moyne Institute of Preventive Medicine it forms the School of Genetics and Microbiology, which is part of the Faculty of Science.
News and Events
-
Seminar by Arnold Munnich
-
Seminar by David Lyons
-
Seminar by Brent Derry
-
Seminar by Stephen Turner
-
A curiosity-driven genetic discovery that should impact cancer treatments
-
M.Sc. Genomic Medicine open for application
-
Ground-breaking scientist, Trudy Mackay, receives prestigious Dawson Prize
-
Ancient genome analyses by Bradley group reveal mosaic pattern of goat domestication